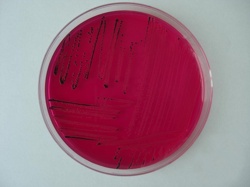
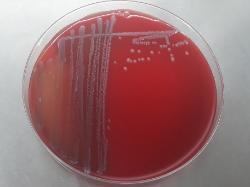

| Hydrogen sulfide produced by Salmonella on XLD agar (black colonies). |
| Genus Salmonella Lignieres, 1900 |
| A: Salmonella Galinarum-Pullorum, Gram-stained, 24h culture. B: same culture after group D antisera agglutination. |
Salmonella enteritidis, Salmonella paratyphi, Salmonella typhimurium and
Salmonella typhi are heterotypic synonyms of S. enterica subsp. enterica. The
epithets enteritidis, paratyphi, typhimurium and typhi should be used only in the
names of serovars.
In subspecies of Salmonella choleraesuis (S. enterica) serovars are recognized
based on the somatic and flagellar antigens. Some serovar names denoted disease
and/or animal host specificity (e.g. Typhi, Abortus-ovis, Abortus-equi) or geographical
area where the first strain of the serovar was isolated (e.g. London, Paris). In order to
simplify the serovar nomenclature, a shortened name is in use: Salmonella and
serovar name (eg. Salmonella Abortusovis), (complete names would be Salmonella
choleraesuis subsp. cholearaesuis serovar Abortusovis or Salmonella enterica
subsp. enterica serovar Abortusovis). Initially, 'O' groups were designated by letters,
later continued by numbers 51 to 67. It is advisable to renounce using letters and to
use only numbers. See the table below:
Salmonella typhi are heterotypic synonyms of S. enterica subsp. enterica. The
epithets enteritidis, paratyphi, typhimurium and typhi should be used only in the
names of serovars.
In subspecies of Salmonella choleraesuis (S. enterica) serovars are recognized
based on the somatic and flagellar antigens. Some serovar names denoted disease
and/or animal host specificity (e.g. Typhi, Abortus-ovis, Abortus-equi) or geographical
area where the first strain of the serovar was isolated (e.g. London, Paris). In order to
simplify the serovar nomenclature, a shortened name is in use: Salmonella and
serovar name (eg. Salmonella Abortusovis), (complete names would be Salmonella
choleraesuis subsp. cholearaesuis serovar Abortusovis or Salmonella enterica
subsp. enterica serovar Abortusovis). Initially, 'O' groups were designated by letters,
later continued by numbers 51 to 67. It is advisable to renounce using letters and to
use only numbers. See the table below:
|
| Salmonella Typhimurium ATCC 14028 colonies on sheep blood agar |
Taxonomy
Morphology
Cultural characteristics
Biochemical characters
Ecology
Pathogenicity
References
Phylum Pseudomonadota (Proteobacteria), Class Gammaproteobacteria, Order Enterobacterales, Family Enterobacteriaceae,
Genus Salmonella.
Two systems of nomenclature are in use for Salmonella species: Salmonella enterica (new) / Salmonella choleraesius (old):
- Salmonella bongori - synonyms Salmonella enterica subsp. bongori, and Salmonella choleraesuis subsp. bongori.
- Salmonella choleraesuis - type species of the genus, heterotypic synonym: Salmonella enterica;
Salmonella enterica subsp. arizonae - synonyms: Salmonella choleraesuis subsp. arizonae and Salmonella arizonae,
Salmonella enterica subsp. diarizonae - synonym: Salmonella enterica subsp. diarizonae,
Salmonella enterica subsp. choeraesuis - synonym: Salmonella enterica subsp. enterica,
Salmonella enterica subsp. houtenae - synonym: Salmonella enterica subsp. houtenae,
Salmonella enterica subsp. indica - synonym: Salmonella enterica subsp. indica,
Salmonella enterica subsp. salamae - synonym: Salmonella enterica subsp. salamae.
- Salmonella subterranea (proposed species), Shelobolina et al. 2005.
Genus Salmonella.
Two systems of nomenclature are in use for Salmonella species: Salmonella enterica (new) / Salmonella choleraesius (old):
- Salmonella bongori - synonyms Salmonella enterica subsp. bongori, and Salmonella choleraesuis subsp. bongori.
- Salmonella choleraesuis - type species of the genus, heterotypic synonym: Salmonella enterica;
Salmonella enterica subsp. arizonae - synonyms: Salmonella choleraesuis subsp. arizonae and Salmonella arizonae,
Salmonella enterica subsp. diarizonae - synonym: Salmonella enterica subsp. diarizonae,
Salmonella enterica subsp. choeraesuis - synonym: Salmonella enterica subsp. enterica,
Salmonella enterica subsp. houtenae - synonym: Salmonella enterica subsp. houtenae,
Salmonella enterica subsp. indica - synonym: Salmonella enterica subsp. indica,
Salmonella enterica subsp. salamae - synonym: Salmonella enterica subsp. salamae.
- Salmonella subterranea (proposed species), Shelobolina et al. 2005.
Gram-negative rods, 2-5 / 0.7-1.5 μm, non-capsulated, non-sporulated.
Colonies are 1-3 mm diameter, S-type, but sometimes R-type colonies may appear.
Motile, with the exception of Gallinarum and Pullorum serovars.
Facultatively anaerobic, growth temperature 37 ºC. Grow easily on various media:
Nutrient Agar or Nutrient Broth, Trypticase Soy Agar ± 5% sheep blood, Mac Conkey
Agar - white/colourless colonies, SS Agar - colourless colonies, Rambach Agar - red
colonies, XLD Agar (Xylose Lysine Deoxycholate agar ) - red colonies, some with black
center, Mueller-Hinton Agar.
Motile, with the exception of Gallinarum and Pullorum serovars.
Facultatively anaerobic, growth temperature 37 ºC. Grow easily on various media:
Nutrient Agar or Nutrient Broth, Trypticase Soy Agar ± 5% sheep blood, Mac Conkey
Agar - white/colourless colonies, SS Agar - colourless colonies, Rambach Agar - red
colonies, XLD Agar (Xylose Lysine Deoxycholate agar ) - red colonies, some with black
center, Mueller-Hinton Agar.
Widely distributed in nature. Isolated from water, foods (raw meats, poultry, eggs, milk
and dairy products, fish, shrimp, frog legs, yeast, coconut etc.), soil, plants, feces,
animal organs & caracases (which may be contaminated during slaughtering and
processing). Also have been isolated from the outside of egg shells.
and dairy products, fish, shrimp, frog legs, yeast, coconut etc.), soil, plants, feces,
animal organs & caracases (which may be contaminated during slaughtering and
processing). Also have been isolated from the outside of egg shells.
Salmonella can infect humans, farm animals, reptiles and others. It is mostly a
foodborne pathogen.
Salmonella strains may produce a thermolabile enterotoxin that bears a limited
relatedness to cholera toxin and a cytotoxin that inhibits protein synthesis. Both of
these toxins are presumed to play a role in the diarrheal symptoms.
Salmonellosis may present one of several syndromes including gastroenteritis,
enteric (typhoid) fever, abortus or septicemia. Salmonella septicemia has been
associated with subsequent infection of virtually every organ (spline, liver, kidney,
lungs, brain, lymphnodes).
foodborne pathogen.
Salmonella strains may produce a thermolabile enterotoxin that bears a limited
relatedness to cholera toxin and a cytotoxin that inhibits protein synthesis. Both of
these toxins are presumed to play a role in the diarrheal symptoms.
Salmonellosis may present one of several syndromes including gastroenteritis,
enteric (typhoid) fever, abortus or septicemia. Salmonella septicemia has been
associated with subsequent infection of virtually every organ (spline, liver, kidney,
lungs, brain, lymphnodes).
- J. G. Holt et al., 1994. Facultatively Anaerobic Gram-Negative Rods. Subgroup 1. Family Enterobacteriaceae. In: Begey’s Manual of
Determinative Bacteriology, 9th-edition, Williams & Wilkins, pp 175-189. - Euzeby J.P.: Revised Salmonella nomenclature: designation of Salmonella enterica (ex Kauffmann and Edwards 1952) Le Minor
and Popoff 1987 sp. nov., nom. rev. as the neotype species of the genus Salmonella Lignieres 1900 (Approved Lists 1980),
rejection of the name Salmonella choleraesuis (Smith 1894) Weldin 1927 (Approved Lists 1980), and conservation of the name
Salmonella typhi (Schroeter 1886) Warren and Scott 1930 (Approved Lists 1980). Request for an opinion. Int. J. Syst. Bacteriol.,
1999, 49, 927-930. - Brenner F.W., Villar R.G., Angulo F.J., Tauxe R. & Swaminathan B.: Salmonella nomenclature (Guest Commentary). J. Clin.
Microbiol., 2000, 38, 2465-2467. - Popoff M.Y. & Le Minor L.: Taxonomy of the genus Salmonella. Changes in serovars nomenclature. In: M.Y. POPOFF and L. LE
MINOR: Antigenic formulas of the Salmonella serovars, 7th revision. WHO Collaborating Centre for Reference and Research on
Salmonella. Institut Pasteur, Paris, France, 1997, p. 5. - Ezaki T., Kawamura Y. & Yabuuchi E.: Recognition of nomenclatural standing of Salmonella typhi (Approved Lists 1980),
Salmonella enteritidis (Approved Lists 1980) and Salmonella typhimurium (Approved Lists 1980), and conservation of specific
epithets enteritidis and typhimurium. Request for an Opinion. Int. J. Syst. Evol. Microbiol., 2000, 50, 945-947. - Don J. Brenner and J.J. Farmer III, 2001. Family I. Enterobacteriaceae. In: Bergey’s Manual of Systematic Bacteriology, Second
edition, Vol two, part B, George M. Garrity (Editor-in-Chief), pp 587-897. - Patrick A.D. Grimont, Francois Xavier Weill. Antigenic formulae of the Salmonella serovars. 9th edition. Paris, France: WHO
Collaborating Center for Reference and Research on Salmonella, Institute Pasteur; 2007. - Adeolu M, Alnajar S, Naushad S, S Gupta R. Genome-based phylogeny and taxonomy of the 'Enterobacteriales': proposal for
Enterobacterales ord. nov. divided into the families Enterobacteriaceae, Erwiniaceae fam. nov., Pectobacteriaceae fam. nov.,
Yersiniaceae fam. nov., Hafniaceae fam. nov., Morganellaceae fam. nov., and Budviciaceae fam. nov. Int J Syst Evol Microbiol
2016; 66:5575-5599.
Positive results for catalase, nitrate reduction, methyl red, acid production from:
glucose, mannitol and D-mannose.
Negative results for indole production, urea hydrolysis, Voges-Proskauer reaction,
phenylalanine deaminase, gelatin hydrolysis, esculin hydrolysis, oxidase, DN-ase,
lipase, acid production from: adonitol, sucrose, cellobiose (most of strains), raffinose,
salicin and alpha-methyl-D-glucoside.
glucose, mannitol and D-mannose.
Negative results for indole production, urea hydrolysis, Voges-Proskauer reaction,
phenylalanine deaminase, gelatin hydrolysis, esculin hydrolysis, oxidase, DN-ase,
lipase, acid production from: adonitol, sucrose, cellobiose (most of strains), raffinose,
salicin and alpha-methyl-D-glucoside.
(c) Costin Stoica

| Antibiogram |
| Encyclopedia |
| Culture media |
| Biochemical tests |
| Stainings |
| Images |
| Movies |
| Articles |
| Identification |
| Software |
| R E G N U M PROKARYOTAE |
|
Differential characters:
Legend: + positive 90-100%, - negative 90-100%, [+] positive 75-89%, [-] negative 75-89%, d positive 25-74% of strains
| Back |
See ABIS online software for Salmonella serovars identification.